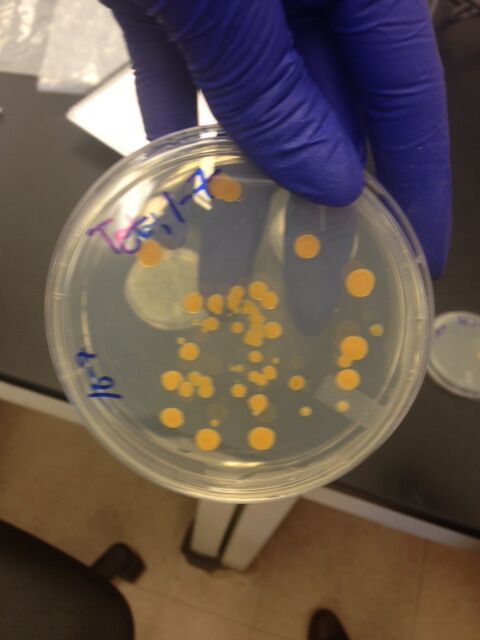
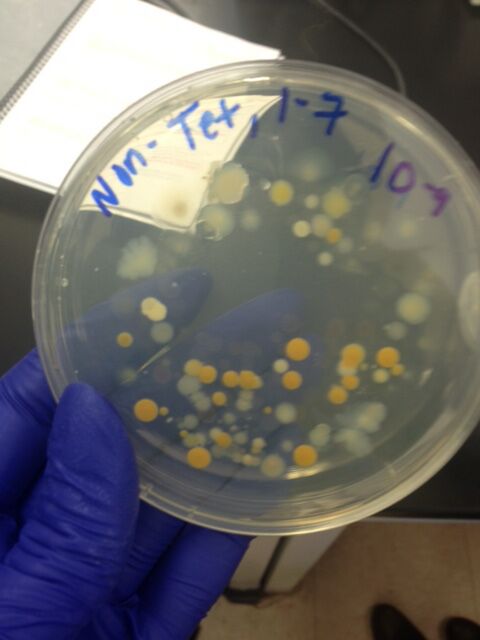

User:Yasmine Yaiche/Notebook/Biology 210 at AU
Extensive Laboratory Observation on Embryology & Development of – 3/13/2015
Purpose:
The following purpose of this lab is to understand the various mechanisms that hinder embryonic growth and development of Zebrafish. Additionally, the purpose is to learn newfound laboratory skills and observation of Zebrafish and to be able to take these skills and apply them to further laboratories where the use of observation for various other organisms is accurate and efficient.
Particularly, for this laboratory each individual is given a set of 20 zebrafish – 10 of which are placed into a control petri dish (water) and 10 placed into an experimental petri dish (salt solution, varies for each group) that which are all observed for 2 weeks. Throughout initial understanding of the lab and research of various biological terms, one can assume that if the zebrafish are placed into a salt solution, then their embryonic development will be hindered based on abnormal alterations to their natural growth. Essentially, if the embryos are exposed to salt, than the embryo will lack sufficient environmental standards to survive (i.e. bacteria, yolk, and development). The complexity of their embryonic development will cease upon arrival to the gastrulation phase (hypothesis) because of the prediction that the saline will impact their growth and development. Key terms to know pre-lab:
• Embryology: Used to describe how the embryo of a species develops based on a sequence of events – after egg fertilization
• Growth: Non-reversible increase in size of the organism
• Differentiation: Based on structure and function of a group of cells
• Morphogenesis: Development of pattern, shape, and form
• Fertilization: When sperm and egg unite to form a zygote
• Cleavage: The zygote divides to increase the number of small cells (Morula)
• Blastula: Hollow sphere of cells – the initial branch from a Cleavage
• Gastrulation: Cells of the sphere formed during Cleavage process, migrate to new positions in the embryo
Materials & Methods:
Zebrafish Experimental Process 1) After creating a hypothesis and prediction as well as reading a published paper about the effect on zebrafish development, we are asked to set up a control group of exactly 20 mL of Deer park water and the test group (20 mL of saline-mixed solution) in covered petri dishes 2) We gather 20 healthy translucent embryos per dish and use a dropper to transfer the eggs. By gathering and setting up our experiment, we are able to begin an organized schedule as to which days are necessary to observe our zebrafish
- Friday – February 20th (DAY 1) a) After setting up the zebrafish on the 19th, we were asked to remove any of the dead eggs (24 hours) and count the number surviving.
- Monday – February 23rd (DAY 4) b) Removal of dead eggs and count the number surviving. We were also asked to remove 10 mL of solution and add 25 mL. Furthermore, we were asked to observe 1 to 2 depression slides and take note of the length per slide, movement, and other necessary variables (under results)
- Thursday – February 26th (DAY 7) a) One drop of food (Paramecium) was added to each dish On day’s 4, 7, and 11, we observed the representative embryos larvae from each plate with the compound microscope and placed a few drops of sample with the organisms in a depression slide and use the 4X objective. Degree of body, tail pigmentation, eyes and eye movement, heart and heart rate, pectoral fin development, yolk sac size, development of the swim bladder, development of the mouth (protruding jaw), and general movement based on startle development were all calculated based on a scale of the way the fish moved or reacted – final results will be mentioned below. b) Three larvae from the control and three from the test dish were preserved by using a dropper to transfer them into a tube and adding one drop of tricaine solution per mL of water. The TA added paraformaldehyde and stored the samples. Again, results on how many are dead and how many are alive is mentioned under the results section. (Steps repeated on Day 14 – 2 week mark)
- Friday – March 6th (DAY 14) a) Check-up on zebrafish prior to leaving for Spring Break showed detrimental results. Ocular micrometer, length, eye diameter, and fin development as well as pigmentation was measured)
Results:
- Friday – February 20th (DAY 1)
a) At first glance, the control zebrafish seemed to have shown an almost 20 –somite stage of growth, yet when zoomed in, the control showed the fish at a 28 hour stage
b) On the other hand, the experimental group showed a 17-somite stage, with some exhibiting a 15 –somite stage.
c) After day 1, 16/20 of the control fish were alive and 17/20 of the salt solution fish were alive. The likelihood of lives and deaths can vary to environment in addition to external environment with the possibility that spilled water of our fishes petri-dish home may have occurred. This is because there is more alive fish in the experimental than the control, which typically is unlikely.
- Monday – February, 23rd (DAY 4)
a) Fish growth was not observed during this day as both partners could not make it, however, fish were preserved until observation in the next 3 days.
- Thursday – February, 26th (DAY 7) a) On day 7, preserved fish from day 4 are observed. b) Observation under 4X for the CONTROL FISH showed a length of 120 ocular units and an eye diameter of 7 ocular units. c) Pigmentation showed a dark green color with a black spinal cord d) Fin development showed a small protrusion of cells, a possible growth of a dorsal fin e) Organ development shows a spinal cord, however body cavity is no longer clear so structures cannot be seen f) Motility shows rapid swimming on a scale of 1 being slow and 10 being quite fast, fish exhibit an 8 with jolted movement g) Observation under 4X for the EXPERIMENTAL FISH showed a length of an egg casing, with all eggs appearing to have burst open but they are on average 50 ocular units in diameter h) Pigmentation is clear
- Friday – March, 6th (DAY 14)
a) At this point in time, all of the samples in the control dish were dead. It seemed to be difficult to even locate bodies due to their state of deterioration (control fish measurements consistent at 4X)
b) No Motility, deceased
c) Length showed 40 ocular units with an eye diameter of 3 ocular units
d) Pigmentation showed a greenish black color, spotted
e) Fin development showed budding of a dorsal fin and organ development was hard to decipher due to deteriorating tissue
Conclusions & Future Directions: In conclusion, the zebrafish experiment showed differing results for each group, yet final results of the majority protruded results of dying fish in both the experimental group and the control group. The passing of the fish in the experimental group was predicted early on as previous tests of these organisms in saline solution concluded results of dying fish by the turn of Blastulation and even Gastrulation stage! Additionally, the fish in the control petri dish may have passed away due to lack of possible feeding or alteration in environment. Future directions includes possibly conducting the days of the experiment throughout every single day of growth and not just certain days (i.e. lab meet-up days) NOTE: Error during the experiment included the professor mentioning that someone may have altered or skewed our fish’s environment because the control environment fish should not have passed as early on as it did. Additionally, snow days at the university halted our laboratory observational experience as some days we could not come in to observe the fish.
YY
The Final Product --> 16s Sequence - 03/5/2015
The Purpose: The purpose of the following Extra Lab is to complete the PCR reaction for 16s sequencing by finding the specific sequence based on a specified tube label (MB21) that corresponds with the tube containing the DNA of our a specific bacterium in our colony such that identification of the genus of the species is finalized and all of the preceding labs are complete. The DNA is isolated from a bacteria derived from the Hay Infusion Culture of the marshland transect.
Materials & Methods:
As mentioned in the lab notebook, we are asked to perform a procedure of selectively amplifying the 16s rRNA gene. The following materials and methods are listed below in order of specified steps in facilitating the experiment and completing it successfully.
1. A single colony of bacteria was transferred to 100 ul of water in a sterilized tube. 2. At 100 degrees Celsius, we incubated the bacteria for at least 10 minuets in a heat block (tubes should be floating in water in the heat block). 3. Samples were then centrifuged for 5 minuets at 13,400 rpm. 4. During centrifugation, 20 ul of primer and water mixture were added into the labeled PCR tube. The tube was mixed in order to dissolve the PCR bead. 5. 5 ul of the supernatant from the centrifuged samples was transferred to the 16S PCR reaction. The tubes were then placed into the PCR machines.
The following week and half (late due to consistent weather delays), the PCR products were ran under an agarose gel. The instructors then purified the DNA for sequencing. Additionally, sequencing was used to identify species by specifically amplifying the rRNA which, in turn, allows one to be able to find the genus through an online BLAST program.
[Bentley, M., Walters-Conte, K., & Zeller, N. (2015). Microbiology and Identifying Bacteria with DNA Sequences. In A Laboratory Manual to Accompany: General Biology II (2nd ed.). Department of Biology, American University.]
Results:
Below is an image of the Agarose Gel:
The species identified is Pseudomonas sp. (ST 6-02 16S ribosomal RNA gene, partial sequence - GenBank: KM253193.1)
Discussion/Conclusion:
According to the following results that identifies our bacteria as a gram-negative, rod-shaped Pseudomonas, we can conclude that the majority of the characteristics of the bacterium that was sequenced matches up with the characterization of our bacteria colony. The only difference would be shape, however motility, arrangement, colony morphology, and gram staining matches up with the early results from previous labs of this experiment. Several issues of inaccuracy arose during the experiment such that improper transfer of the bacterium to amplification was faulty (mentioned by laboratory partners); however, one can conclude that the lengths of this experiment can sometimes lead to small error where identification of an organism or small faults throughout the experiment are OK, as long as adjustments and fixations are made - if not possible, taken into consideration for the skewed lab results for the rest of the experiment. However, collectively, the experiment proved to be a success and an exciting learning experience to be able to start from square 1 of a transect and collect a plethora of samples, to only proliferating and understanding one.
YY
Vertebrates and Niches - 02/14/2015
The Purpose: The purpose of the following Lab V - part B is a final element that collectively ties the entire five corresponding lab experiments together. Essentially, by being able to identify various organisms in our transect - bacteria, to plants, to invertebrates - new knowledge and understanding will further allow us to finalize the entire experiment The purpose of vertebrates in our niches is to consider the fact that they may inhabit and pass through our transect; thus, is a necessary component to understanding the legitimate organisms at the top of the food chain and its contributions symbiotically to the rest of the organisms identified in the previous four labs. Although, observation of these larger animals and their droppings/footprints have not been identified, the entire transect is still an option for representing the importance of a single niche or part of a niches contribution to an entire ecosystem.
Materials & Methods:
Although not many materials or methods can be identified at this time, similar procedures and materials were used from part A of this lab, because observation of any creatures that may be present would be found among the soil of the leaf-litter. Additionally, a more precise method of finalizing whether vertebrates are present in the grounds of our transect were based upon pure observation of the environment around us. Individually (and on our collective time schedule), I ventured off to the transect location this morning. As a simple procedure, I noticed that the weather was quite cold (about 21 degrees Fahrenheit) at approximately 8 AM. The sun had just risen and I hadn't noticed very many vertebrates passing by. My method of choice for this was to take note of any animal footprints found and come back later. Due to excessive leaf coverage over the soil grounds, I decided it would be best to come back later in the day. As an ulterior method, I decided it would be much more efficient to come later in the day when the temperature had slowly risen and the sun was shining. By arriving at the transect location at approximately 2 PM with a 10 degree temperature increase, I was able to find five vertebrates present - this will further be identified and described in the upcoming data section.
Data/Results:
Listed below are 5 vertebrate species found on the Marsh Land transect that are classified by their phyla and the specific whereabouts on the transect (Pictures will be found in the food chain):
1) Song Sparrow - Family Emberizidae, Genus Melospiza, Melospiza melodia --> Found on the ground near several rocks and short grass
2) Eastern Chipmunk - Genus Tamias, Tamias Striatus --> Found on a large rock with moss on and surrounding it
3) Grey Squirrel (Black Color) - Sciurus Carolinesis --> Found chasing an Eastern Fox Squirrel
4) Eastern Fox Squirrel - Phylum Cordata, Sciurus Niger --> Found chasing the Grey Squirrel
5) Bald Eagle - Genus Haliaeetus, Order Accipitriformes, Haliaeetus Leuciceorialis --> Found flying over transect location making screeching noise = most likely sighting for food to prey on
Discussion:
As questioned in the lab journal, there are certain biotic and abiotic characteristics of the transect that would benefit each of the species. As a abiotic feature, the dead leaves, branches and sticks, rocks, and soil was used by one of the birds to build a nest, as it continuously flew back and forth from the transect throughout the 15 minuets of my presence observing the area. These biotic features are necessary in aiding any species in building a nest. Additionally, I found that the chipmunk was resting on a rock where moss was present. After less than 30 seconds, the chipmunk ran into the shrivel of biotic plantae (i.e. cat tails and wheat), which may have been a place it along with any other creatures may live. As far as the brown and black squirrels, they were just chasing each other around the transect and ran to a tree across the sidewalk. Ultimately, the abiotic and biotic features can provide for them in terms of building a home or for any defense mechanisms/camouflage goals;however, they were simply just running around in circles. Likewise, this pertains to the eagle which was found flying over the transect and making screeching noises - most likely searching for any biotic or abiotic food items around the transect.
--> Below is a food chain on all of the organisms observed in the transect:
(The Eagle is representative of a LEVEL 1 - top of the food chain image. Typically, Level 1 depicts carnivores at the top of the food chain. Level 2 then reaches the vertebrates found in the transect who, in this case, are herbivore or arthropod eaters. Level 3 identifies the various plantae found in the transect. Within level 3 is a two-branch system of level 4: representing the invertebrates found within the soil of the transect, and level 5, which represents the bacteria found throughout the transect of the soil, leaves, moss, etc.
Essentially, these organisms represent the ecological concepts of community because they each contribute to the food chain of an ecosystem. Whether they feed off an organism or are fed on, whether they contribute to an organism in a symbiotic or mutualistic/parasitic manner, and whether they just pass through, they still leave a mark on that ecosystem that essentially creates an ecosystem full of species that evolve, have evolved, or are in the process of evolving/adapting. From bacteria to vertebrates, these organisms contribute to the ecosystem of a community in a collective manner - essentially, it is just based upon the works of life.
Given the food, water, habitat, and overall nature vs. nurture state of a habitat, the carrying capacity of these organisms contributes to the overall theory of a community and evolution. As the food web shows, the vertebrates may be herbivores or carnivores feeding off of any of the lesser organisms below them in the food chain. Likewise, these organisms could be benefiting, hurting, or neither affected nor hurt from the environment - however the way they die off or the way their particular population increases contributes to the carrying capacity. Imagine the influx of brown squirrels to black squirrels where brown feeds on the same types of foods as black, however black may be living differently. Ultimately, if the environment can not suffice to feed both phyla of these squirrels, the squirrels begin to die off. Once enough of the squirrels die off, the food item (i.e. grass or acorns) may increase, and the cycle will repeat. Although certain conditions (i.e. weather) can impact the environment, the cycle is still on-going and repeated among all other species in the food chain. Similarly, the trophic levels (what an organism eats and what eats it) can effect the carrying capacity and overall community of the population. Under extreme measures, this is when certain organisms can become extinct.
YY
Invertebrates and the unique presence of their existence in a Marsh Land transect - 02/12/2015
The Purpose: The purpose of the following Lab V - part A is to understand the importance of invertebrates and to collectively be able to learn how such simple systems have evolved into complex ones. Furthermore, the purpose of this lab is to be able to understand the various symmetries (i.e. radial and bilateral) in addition to studying the soil invertebrates found from our transect and identifying whether they are arthropods, microarthoprods, or any other type of organism - all of which will be found from the bottom contents of the Burlese Funnel.
Materials & Methods:
SET-UP FROM PREVIOUS LAB --> BERLESE FUNNEL TO COLLECT INVERTEBRATES 1) Pour about 25 mL of the 50:50 ethanol/water solution in to the 50 mL conical tube 2) Take a piece of the screening material and fit it into the bottom of the funnel. Then, tape the sides of the screen (if needed), so the leaf litter does not fall into the preservative 3) Cautiously, put the leaf litter sample at the top of the funnel and set up the ufnnel on a ring stand such that it is held into the tube with the ethanol. 4) Parafilm the base of the funnel and the tube so the ethanol won't evaporate. 5) The professor will place a 40 watt lamp above the funnel with the incadescent bulb, roughly a few inches from the top of the leaf litter. Everything must then be covered with foil.
(The Berlese Funnel will be left on the lab bench for one week - The organisms from the leaf litter will essentially stray away from the heat and directly fall into the 50% ethanol, which will be used and tested in the Invertebrate lab).
Figure 1:
- Procedure I: Coelomates, Acoelomates, and Pseudocoelomates This procedure is vital to performing a method of pure observation, such that understanding these particular organisms and how they look like will lead to better understanding how our particular organisms may be similiar or different. We are asked to observe the acoelomate, Planaria with a dissecting scope, which becomes the main material throughout this lab. The method of identifying the movement is key to identifying whether an organism may be alive or dead.
a) When asked to observe the coelomate, Annelida (a pink-like worm), position of the internal organs and the layers of the muscle were noted. Essentially, by performing the method of observation of these three types of worms, their movement in relation to their body structure showed an evident depiction of a clear, slimy, small, and slithery creature.
- Procedure II: Arthropods & Basic, corresponding knowledge A plethora of the invertebrates observed from the transect were (before knowing - will be) arthropods, thus knowledge on these interesting fiends will benefit the experiment by allowing one to learn more about the classes and orders of these organisms. Under the instruction of the lab director, we were asked to observe the example organisms from each of the five major classes (i.e arachnids, diplopoda, chilopoda, insect, and crustacea). Ultimately, observation of these organisms in addition to using a "dichotomous key" for these organisms will allow one to better understand the exact organism that will be found in the ethanol portion of their Berlese Funnel.
Figure 2:
- Procedure III: Analyzing the Invertebrates Collected with the Berlese Funnel
1) Break down the funnel and slowly pour the top 10-15 mLs of liquid and organisms into a provided petri dish. 2) Pour the liquid into a second dish and examine both using a dissecting microscope (debris may be present) 3) Identify any Arthropoda invertebrates observed.
- Data on the five invertebrates found and their corresponding information will be found under the data section of this lab entry.
Data:
The following table defines data collected of five invertebrates found within the leaf litter and dropped into the ethanol sample. The table reflects the organism (phylum and class), length in mm, number found in the sample, and the description of the organism in terms of motility, color, and shape.
Figure 3:
Conclusions & Future Directions:
At this time, conclusions can be made as their is evidence under observation of various arthropods in our transect. Further directions would be to gather a larger leaf-litter sample such that identification and characterization of various invertebrate species will provide a conclusive turn-out of a more diverse ecosystem that could potentially be present in various parts of the transect; parts that may otherwise not be collected with such a limited funnel space/time.
YY
The Diversity of Plants and Fungi at your local college campus - 02/5/2015
The Purpose: The purpose of the following Lab IV is to identify and study plants that have evolved from aquatic green algae which may relate to the Bryophytes, Tracheophytes, and Angiosperms - all of which are plant species that have diverged from each other and have dated back for billions of years. Collectively, the overall purpose of this lab is to observe the characteristics of a Bryophyte moss (Mnium), Angiosperm (Lillium), as well as five plant samples from our own individual transect (marsh lands). The purpose of collection and observation of these particular plant organisms is to be able to identify and characterize the presence of Vascularization, Specialized Structures, and Mechanisms of Reproduction.
Methods & Materials: (Courtesy of Biology 210 Laboratory notebook)
- Procedure I: Collection of five plant samples from the Marsh Land Transect
1) Obtain three Ziploc Bags to collect various samples from the marsh land transect 2) Obtain a leaf litter sample from the transect where soft soil and dead leave or ground cover over it. Use these dead leaves and plant matter as well as only a little of the crumbly top layer of the soil. Then, instructions required us to place about 500g of leaf litter into one bag to later set up the Berlese funnel for collection and identification of invertebrates in the following lab (Methods to setting up the funnel will be described in Lab V).
- Procedure II: Plant Vascularization In our groups, we were asked to compare the moss with the stem of an Angiosperm to further understand plant vascularization. These plant materials were provided by the lab instructor and observation was just a simple laboratory method or procedure to further be able to compare/understand the plant vascularization of our own five samples.
- Procedure III: Identifying the Presence of Specialized Structures The goal of this particular procedure is that through provided materials of dissection scopes and a compound scope, our method was limited to observation of the leaves of moss and to further comprehend their distinct stems, cuticles, outer surfaces, and knowing the shapes, sizes, and cluster arrangements of the leaves from the transect plants.
- Procedure IV: Mechanisms of Plant Reproduction A lily flower was provided by the instructor such that we were asked to perform the method of dissecting and identifying its counterparts. This includes understanding the anther, grains of pollen, flower stigma, in addition to the style of the flower. Furthermore, methods of dissecting lab seeds and seeds from our transect are all mechanisms to better identifying our own transect samples.
- Procedure V: Observing Fungi Once again the mechanisms behind observing the various types of plants and fungi in addition to the components that accompany them is simply a motive of pure knowledge and future referral in understanding your personal sample. Materials given with this procedure is various types of fungi (i.e.Fungi Sporangia or "black-bread mold". The method with this procedure includes observation of the fungi under a dissecting microscope.
Data:
The following table is a reflection of of five transect samples collected as a means to explain and identify the location and number of these organisms in the transect, the description (size and shape), vascularization, specialized structures, and mechanisms of reproduction.
Figure 1:
Conclusions and Future Directions:
Further conclusions in terms of discovery of invertebrates from the Burlese funnel will be mentioned in the next invertebrate lab; however, the discovery of the mechanisms of reproduction in terms of diversity and the fact that all five samples do contain a motive of transportation of nutrients and water through vascularization is evidence of the evolutionary plantae kingdom since its arrival a billion years from today. No future directions to change or revise any error and issues from the lab is needed to be concluded at this time.
YY
The Scientific Phenomenon of Molecular Microbiology and Identifying Bacteria with DNA Sequences - 01/29/2015
The Purpose: The purpose of the following Lab III is to comprehend Prokaryotes under the Bacterial domain. Domain Bacteria consists of Proteobacteria, Chlamydiae, Spirochetes, Actinobacteria, Firmicutes, and photosynthesizing Cyanobacteria. We are asked to observe whether any of the Archaea species will have grown on the agar plates and to furthermore, classify these species based upon the bacterial shapes of bacillus (rod-shaped), coccus (spherical), and spirillum (twisted spiral). Additionally, several procedures ask us to quantify and observe these microogranisms based upon the 100-fold Serial Dilutions as well as their resistance to Antibiotics. The purpose also condemns the student to understand another way to differentiate microorganisms based on staining characteristics through a Gram-positive/Gram-negative approach. In using and understanding the purpose of the lab, once can hypothesize that there will be growth on the petri dishes such that if the bacteria is spread throughout the plate accordingly then growth fill appear and will lead us to our next hypothesis of our sample representing both Gram-Positive and Gram-negative stains because of the plethora of organisms that may be present within that organism.
LAST OBSERVATION ON HAY CULTURE BEFORE DISPOSAL:
Sample seems to contain a feces type smell in addition to a brown color. The moss that was once present in the sample is no longer present (seems to have broken apart). Water line indicates evaporation has occurred. The culture may have such an appearance or smell because of the amount of time it has been contained and any organisms that may have died while remaining in the sample. Additionally, change of temperatures in the room may have altered the way this organism lives in addition to the mold from the moss, melting into the sample.
Materials & Methods: - Microscope, which was used to examine the staining techniques of our unicellular organism as well as examining the kinds of organisms present in the growth sections on our agar plate - Agar plate to place our organisms using an inoculating loop and spreader to later observe growth, after incubation period - Staining Kit (includes Ethanol, Iodine, crystal violet, safranin, kimwipe, water, loop, staining tray, flame, and slides)
a) Inoculation loop is sterilized over a flame and a scrape of growth from the surface of the agar is mixed into a drop of water. b) The slide is then heat-fixed over a flame, approximately three times with the bacterial smear side up. c) By using a staining tray, the bacterial smear should be covered with crystal violet for one minute. The stain should then be washed off with water. Repeat this step with Gram's iodine, then decolorize by flooding the smear with ethanol for a few seconds. d) Cover the smear with safranin stain for 20-30 seconds, then rinse off. Blot any unneeded, excess water with a kimwipe and from there, the sample can be observed under 40x and 100x oil immersion.
Set up PCR for 16S sequencing:
The Purpose of setting up a polymerase chain reaction using one nutrient agar plate and one tetracycline plate, such that the DNA will be isolated from the bacteria in the colonies and use primers and PCR to amplify the 16S rRNA gene.
1. Transfer a single colony of bacteria to 100 microliters of water in a sterile tube 2. Incubate at 100 degrees Celsius for 10 minutes in a heat block and make sure that the tubes are floating in water in the heat block 3. Centrifuge samples for 5 minutes at 13,400 rpm 4. During the centrifugation, add 20 microliters of primer/water mixture to a labeled PCR tube. Mix to dissolve the PCR bead. 5. Transfer 5 microliters of supernatant from the centrigufed samples to the PCR reaction and place the tube into the machine. Observation for this reaction will come in more detail next week.
Data:
- Procedure I:
Table 1: 100-Fold Serial Dilutions Results: Growth on the agar plates is observed and colony morphology of the species is characterized below.
Dilution Agar Type Colonies Counted Conversion Factor Colonies/mL 10^-3 nutrient Lawn x10^3 N/A 10^-5 nutrient Lawn x10^5 N/A 10^-7 nutrient 90 x10^7 900000000 10^-9 nutrient 53 x10^9 5.30E+10 10^-3 nutrient + tet 75 x10^3 75000 10^-5 nutrient + tet 2 x10^5 200000 10^-7 nutrient + tet 40 x10^7 400000000 10^-9 nutrient + tet 11 x10^9 11000000000
- Procedure II: Antibiotic Resistance
According to the data, there are differences in the colony types between the plates with versus without antibiotic. When antibiotic is present, the growth is limited, rather indicative of scattered bacterial spots. When the antibiotic is not present, a lawn is shown. This indicates that when an anti-bacterial is present, then the bacteria have no chance to grow due to possible limited exposure to a medicinal. On the other hand, the tetracycline plates showed growth - not near as close as a dilution of 10^-3 lawn colony Nutrient agar, however still consistent with growth. This indicates that the bacteria growing in the presence of tetracycline could potentially be insensitive.
Figure 1:
Figure 2:
Figure 3:
Figure 4:
- Procedure III: Bacterial Cell Morphology Observations
Table 2:Bacteria Characterization
Colony Label Plate Type Colony Description (diameter, color, shape, texture) Cell Description (Motility, Shape, Arrangement) Gram + or Gram - 10^-9 Non-Tet Lawn-yellow, circular, grainy under microscope No motility Negative (Pink) 10^-5 Non-Tet Lots of Colonies - Lawn Spherical Shape Negative (Pink) 10^-5 Tet Circular, Orange, Smooth, Glistening Streptococci motile, move in sync Positive (Purple) 10^-7 Tet Circular, Orange color --- Negative (Pink)
Figure 5:
Figure 6:
Figure 7:
Figure 8:
Conclusions & Future Directions:
The final results show bacteria under the microscope that all display motile abilities and represent live growth in the slide. Further conclusions on identifying these species will be finalized once the PCR products on an agarose gel is run. If there is a product, purification of the DNA for sequencing will occur. Once the samples are sequenced, then identification of our bacteria will be concluded.
Future directions can be steered towards making sure any error in the experiment made is corrected. In the case of performing the PCR, an important reminder would be to keep in consistency with following steps correctly.
YY
Understanding Algae & Protists through a Dichotomous Key perspective – 01/25/2015
The Purpose: The purpose of the following Lab II is to familiarize ourselves with Unicellular Eukarya and to further identify the two large groups it entails: Algae and Protists. Furthermore, the purpose is to understand how to use a Dichotomous Key by obtaining an organism and focusing in on the organism under the microscope. In regards to a continuation from our lab I to this current lab, we are asked to observe our Hay Infusion Culture by gathering two inter-samples from the surface of our sample and from the interludes of our sample (i.e. the surface of the moss for my sample). The purpose for this is to just observe what we see under the microscope and use the Dichotomous Key to identify what seems to be living in our sample. It is believed that if we gather smaller samples from our Hay infusion culture then we will be able to clearly identify more organisms in our culture. It is predicted that there will be a plethora of organisms found in our culture (at least 4 different organisms confirmed through identification via the Dichotomous Key).
Materials & Methods: - Sample of Red Algae and Brown Algae to initially identify and understand what a protists or algae may look like under the microscope and how we can use this image to further identify the organisms scientific name through a Dichotomous Key - Dichotomous Key = given to us to understand the various organisms that could potentially be present in our sample.This key is typically a paper sheet and is listed below as a means of classifying these organisms. - Microscope = used to identify class examples of protists and algae as well as our own personal sample. Throughout lab it is KEY to begin at 4x and further proceed onto 10x and 40x. Some organisms are difficult to find under 10x and others under 40x - this is because of the likelihood that the organisms may be moving at a quick pace. In this case, using a special dilution drop will allow for accuracy in observation. - Hay Infusion Culture = which includes a mixture between our sample, deerpark water, and dried milk - Petri Dish plating of our sample in order to further confirm the existence of these organisms and the impact of its growth once placed in an incubator (this is to test what selective pressures would affect the community of our sample).
- How to perform the preparation/plating of Serial Dillutions: 1) Four tubes were provided in class (and should be provided by the professor). These tubes hold 10mL os sterile broth each with 10-2,10-4, 10-6, and 10-8. These tubes are labeled and a micropippetor (set at 100 mL) is used to administer the broth into the agar plates. The method of using the micropippetor is to increase accuracy in terms of how much of the broth makes it to the plate.
2) Eight plates are provided by the professor - exactly 4 nutrient agar and 4 nutrient agar plus tetracycline. Each of the four plates are labelled as 10-3, 10-5, 10-7, and 10-9. The reason these plates are labelled with a digit above that of the tubes may be due to slight error. Either way, the administration of the broth's into the plates are labeled in chronological order.
3) Therefore, the 10-2 broth is administered into the 10-3 broth, the 10-4 broth is administered into the 10-5 broth, and so-on.
- To administer the broth onto the plate, one must obtain a inoculate "tube" that is sterilized once placed in a lit-fire or gas-exchange. This is to kill any unwanted bacteria from making it into the plate and affecting results. This inoculate sterilized tool is used to swirl the Hay Infusion Culture around the petri-dish to maximize growth accuracy. (KEY: ONCE YOU HAVE HEATED THE INOCULATION TOOL, DO NOT PLACE INTO THE BROTH-PLACED PLATE --> THIS WILL BURN THE BACTERIA AND THEREFORE KILL IT - WAIT A FEW SECONDS)
4) Repeat the procedure on each plate by placing the broth onto the petri-dish and then using the inoculation tool to spread it around the plate - the professor will be able to help, such that any questions arise.
5) The final step is to place the agar plates on a specified rack where incubation for exactly one week will take place (room temperature).
Data:
When observing our sample under the microscope, we found that a majority of the sample embodied various organisms rather than one. This can create another assumption, rather prediction, that a plethora of places where biological life may be found (i.e. Marsh environment), contains an abundance of various protists or algae life. This is confirmed through observation under the microscope and collected data through identification via a Dichotomous Key. After identifying the organisms under the microscope, we found that sample 1 (surface water of our culture) displayed Paramecium Caudatum (280-300 micrometers in length), Colpidium (50-70 micrometers), Bursaria Truncatella. In Sample 2 (just beneath the moss sample found at the bottom of the culture) Vorticella, Paramecium Aurella, and Chlamydomonas, were three of the many organisms found in this section of the culture.
The following Data entails several images gathered from lab that are important in displaying what was done and/or seen during the experiment. Two images display the Dichotomous Key as a basic visual on the various organisms that could be found (organisms in our sample are listed above - try finding these organisms in the Dichotomous key!). Additionally, one image displays a birds-eye view to show the surface of the water, whilst another shows where our moss sample was taken at the bottom of the jar, prior to observation under the microscope. One other picture is a caught image of a trial-and-error of the Paramecium Caudatum at 10x - exciting stuff!
Figure 1:
Figure 2:
Figure 3:
Figure 4:
Figure 5:
Conclusions & Future Directions:
Conclusions cannot be deciphered at this time as the lab is still non-complete, however predictions of possible conclusions are mentioned above. Any possible future directions for this lab could be to gather more areas from our hay infusion culture by not only the surface or bottom of the culture but also from any plant-like material found in the sample.
YY
Earth’s Diversity through Natural Selection: A close look at Biological Life at AU – 01/24/2015
The Purpose: The purpose of the following Lab I is to observe three important organisms classified under the Volvocine Line and the significance of these organisms that happened to be found around various places around campus. The overall focus is geared towards the evolutionary specialization of members of the Volvocine Line, which entails the number of cells, colony size, specialization of the cells, mechanisms of motility, isogamous or oogamous characteristics, as well as understanding the view of these organisms under the microscope and its contribution to biological life through diversity in the ecosystem. Furthermore, a sample from the environment of AU will collected and tested/observed within the span of the next two labs. The Purpose of this is to understand biodiversity and its complexity in places as simple as moss or soil.
Collectively, classmates were operated into assigned groups and told to go to one specific place on campus that represents that of possible selective pressures that may contribute to increased complexity of the organism in its environment. In regards to my group, we were asked to go to a location of Marsh lands (mixture of moss, heavy soil, and collective rocks, wheat, and abiotic features in front of Kogod Business School). It is hypothesized that if a sample is collected into a tube half filled with soil from the marshy ground and half filled with botanic items such as damp moss, leaves, as well as particles from flowers found buried on the ground, that there will be a biodiversitized combination of protists, bacteria, and plant invertebrates in our sample. It is predicted that after using a Hay infused culture into our sample, that some sort of protest may grow within a span of the next week.
Materials & Methods: - Chlamydomonas, Gonium, and Volvox Samples 1) Chlamydomonas: Considered the origin of multicellular evolution in the Volvocine line. The specialization of cells are reproductive, rather vegetative. The mechanisms of motility consist of Flagella and they are isogamous. Information such as this is key to understand to better perform this lab and to better understand the organisms one is working with.
2) Gonium: Colony size is larger and mechanisms of motility are the flagella. These organisms are isogamous.
3) Volvox: These organisms require the use of a depression slide. Though they are vegetative and consist of reproductive cells, these organisms are oogamous. Use of a droplet to control movement of the fast-paced organisms are recommended to be able to better observe these organisms.
- Transect (Marsh Land in front of Kogod) a) Moss b) Dead leaves/grass c) Dead flowers and live petals from flowers d) Mixture of fertilizer and damp soil (previously rained) e) sticks - Microscope - Deerpark Water - 0.1 gm dried milk - Sterile 50 mL conical tube - Microscope
Methods regarding the Hay Infusion Culture Procedure:
1) Place about 10-12 grams of the ground/soil vegetation of your sample in the plastic jar provided by the lab instructor. 2) Add about 500 mL of deerpark water to increase chances of visualization of these organisms and any growth that may occur. 3) Add 0.1 grams of dried milk and close the jar. Mix the contents for about 10 seconds. 4) Remove the lid and place the jar in a safe place (labeled as well) so that the oxygen has a chance to reach any organisms in the jar.
- By next lab: You will be able to observe and find a better "picture" of any organisms in your sample.
Data:
Map of Transect Location – The following are two images that exhibit the marsh environment through two parallel, yet different views. The picture exhibits the wheat, the marshy soil (zoomed out), the sticks, dead leaves, rocks, and all of the biotic/abiotic features.
Figure 1:
Figure 2:
List of 5 Biotic/Abiotic features in Transect Location:
Biotic – Green Fallen Leaves, Grass, Moss, wheat Stocks, Bacteria or living organisms under the soil
Abiotic – Sedimentary Rocks, snow, cement, sewage, metal sign planted into the transect location, trash with food items thrown around the transect (candy wrappers)
Conclusion: Conclusions cannot be made at this time as the experiment is still in the process of completion, however future directions should be to allow the student to observe organisms in a transect environment fairly different from the grounds of American University as similar chemicals are used around campus (i.e. fertilizer, plantations, etc.) that may kill or affect testing for any protists in the environment – this could ultimately alter biodiversity in the environment as well.
YY
01/21/2015
I would like to study Virology or Pathophysiology/Microbiology in the near future.
YY